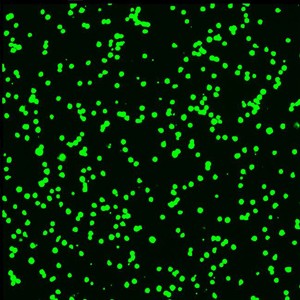
Application Cell viability

Live/dead/apoptotic cells
Application
Live/dead

Live cells are white.
Dead cells are black.
Tryphaneblue stain.

EAZYREADER® 7000
World's first 100 % scalable Elispot/Plaque Reader that may be upgraded on-site to a Single Cell/PBMC counter.
Application
Cell viability
6-CF appears as green fluorescence.

EAZYREADER® 7000
World's first 100 % scalable Elispot/Plaque Reader that may be upgraded on-site to a Single Cell/PBMC counter.
Application
Live/apoptotic cells

NUCblue/interference/NUCgreen.
Mix of Jurkatcells untreated cell proliferate and TNF/CHX-treated that causes to apoptosis.

EAZYREADER® 7000
World's first 100 % scalable Elispot/Plaque Reader that may be upgraded on-site to a Single Cell/PBMC counter.
Application
Transgene assay

"In its most precise usage, the term transgene describes a segment of DNA containing a gene sequence that has been isolated from one organism and is introduced into a different organism."
[https://en.wikipedia.org/wiki/Transgene]
Cells transfected with an expression plasmid encoding eGFP.

EAZYREADER® 7000
World's first 100 % scalable Elispot/Plaque Reader that may be upgraded on-site to a Single Cell/PBMC counter.
Application
Live single cells

Bright field application Jurkatcells.

EAZYREADER® 7000
World's first 100 % scalable Elispot/Plaque Reader that may be upgraded on-site to a Single Cell/PBMC counter.




